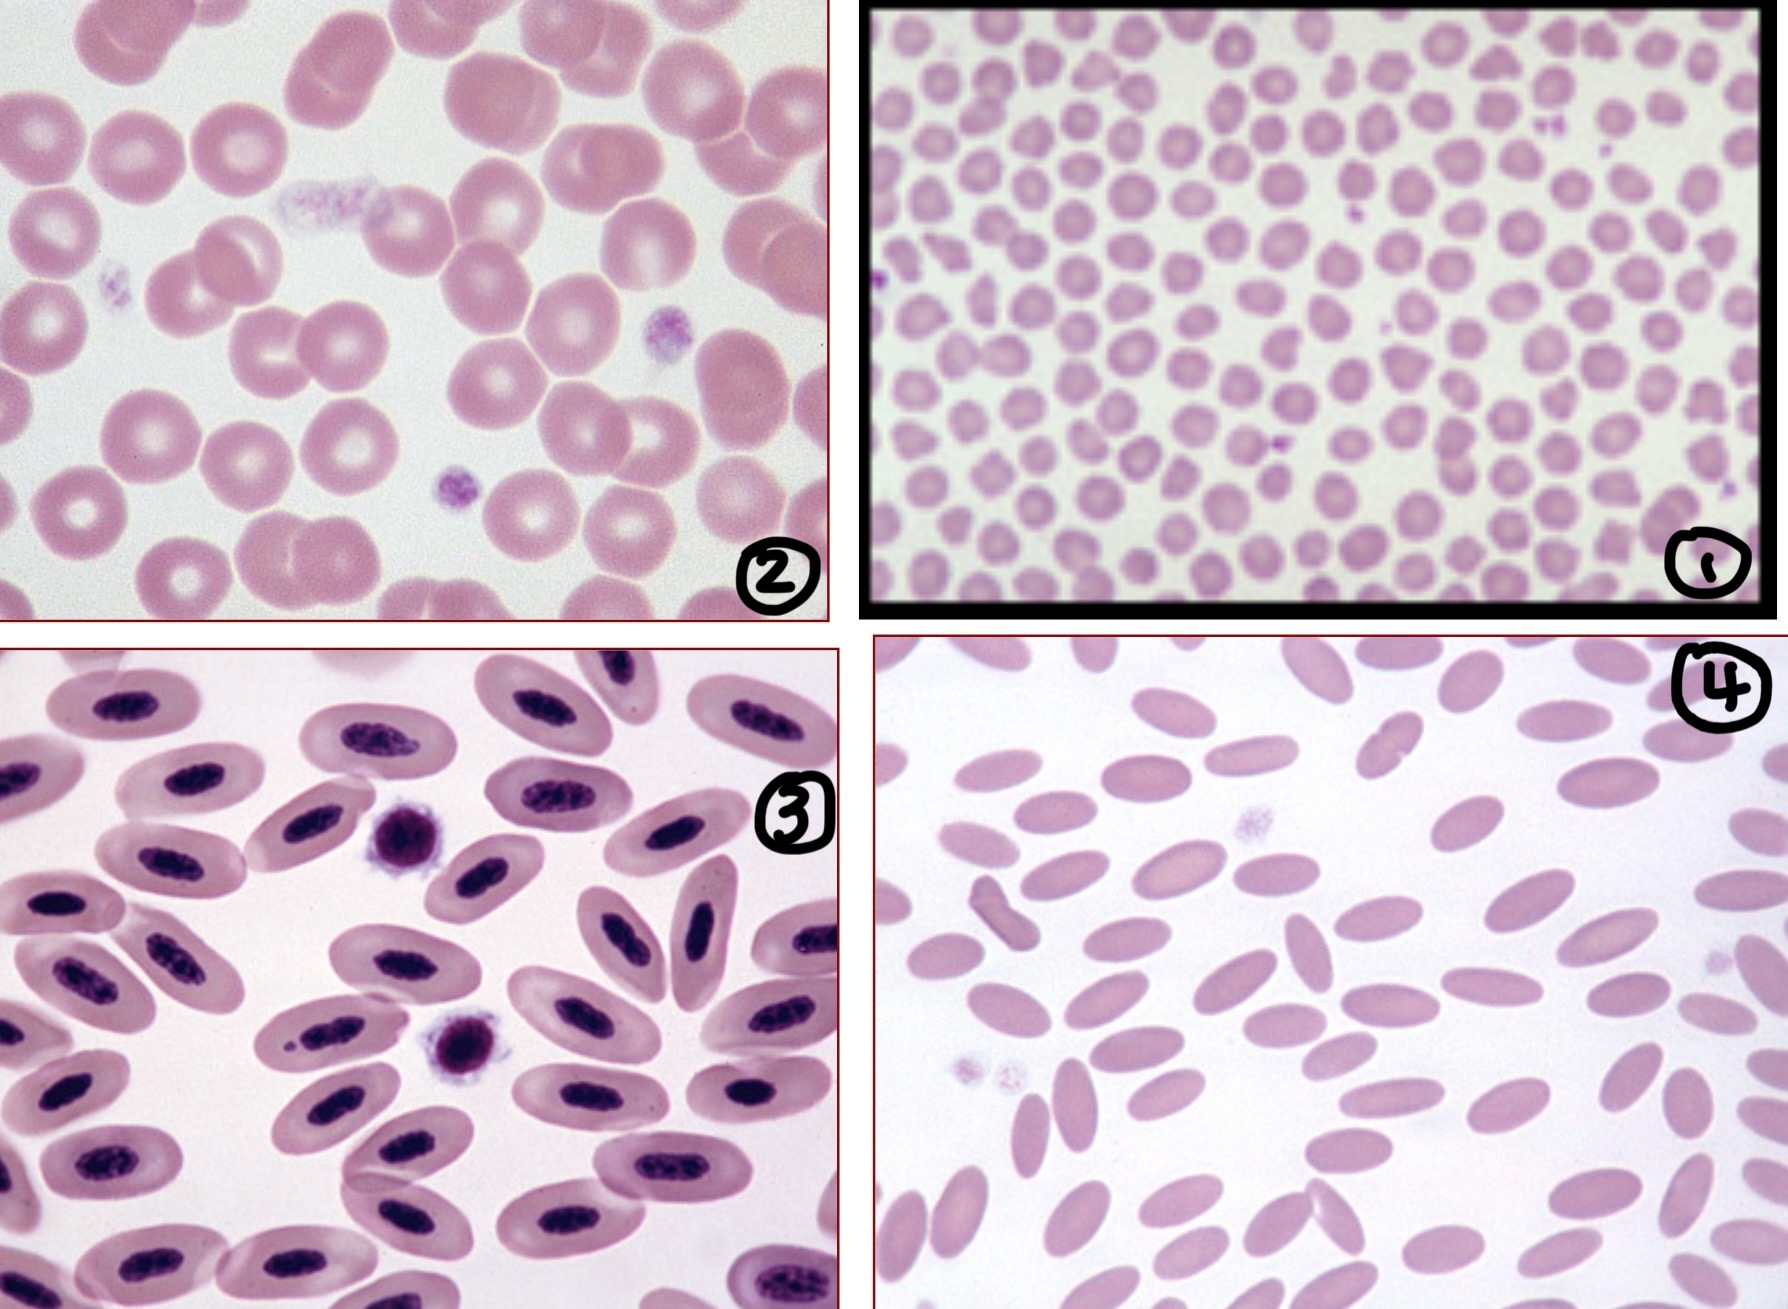
<p>Identify species associated with each RBC </p>

1/25
These flashcards cover essential vocabulary related to blood cells, their functions, morphology, and the process of hematopoiesis.
Name | Mastery | Learn | Test | Matching | Spaced |
|---|
No study sessions yet.
Plasma
The liquid component of blood, making up 54% of total blood volume; contains 91-92% water and various solutes.
Erythrocyte
A type of blood cell that carries oxygen; mammalian erythrocytes are biconcave discs and do not have nuclei.
Anisocytosis
Variation in red blood cell size, commonly found in most species.
Poikilocytosis
Variation in red blood cell shape, which is not common but can be found in certain species like goats and deer.
Reticulocyte
An immature red blood cell that contains RNA and polyribosomes, indicating regenerative anemia when present in high numbers.
Howell-Jolly Bodies
Nuclear fragments found in red blood cells, typically seen in low numbers but can increase after splenectomy.
Heinz Bodies
Precipitated hemoglobin seen in red blood cells under oxidative stress conditions, often associated with hemolytic anemia.
Megakaryocyte
A large bone marrow cell that produces platelets through cytoplasmic processes.
Left Shift
A response to increased demand for neutrophils leading to the release of immature forms (band cells) from the bone marrow.
Erythropoietin
A hematopoietic growth factor that stimulates the production of red blood cells by prolonging the survival of erythroid precursors.
Thrombopoietin
A growth factor that regulates the development of megakaryocytes and platelet levels in blood.
Neutrophil
A type of white blood cell that is the first line of defense and plays a key role in phagocytosis; constitutes 40-70% of leukocyte count.
Monocyte
The largest type of white blood cell, agranular, which can differentiate into macrophages and generally constitutes 3-8% of leukocytes.
Lymphocyte
A type of white blood cell that is pivotal in immune response; comprises 20-40% of leukocytes in dogs and cats and up to 70% in some ruminants.
RBC Sizes
Dog - 7ųm
Cat - 5.8 ųm
Horse - 5.7 ųm
Cattle - 5.5 ųm
Goat - 3.2 ųm
Identify species associated with each RBC
Mammalian - bison cave disc with central parlor
Sheep
Amphibians, Reptiles & Birds - oval shape with nucleus
Camel - oval shape
Cow RBC Lifespan
160 days Sh
Sheep RBC Lifespan
150
Horse RBC Lifespan
145 days
Goat RBC Lifespan
125 days
Dog RBC Lifespan
120 days
Pig RBC Lifespan
79 days
Cat
73 days
Camelidae Lifespan
60 days
Bird Lifespan
35 days